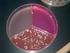
PRÁCTICA No. 4 Métodos de cultivo y descripción morfológica de hongos Introducción

PREPARACIONES Y TINCIONES
|
|
|
- Óscar Ramos Vargas
- hace 8 años
- Vistas:
Transcripción
1 PREPARACIONES Y TINCIONES
2 PREPARACIONES En fresco Temporales: Microcultivos de hongos, preparaciones de tejidos Fijas: Gram, Ziehl Nielsen, Sheaffer y fulton, SEM, TEM, naranja de acridina.
3 CONTRASTE DE FASES
4 PREPARACIONES TEMPORALES: microcultivo de hongos 1. Colocar en una caja de petri, un soporte para portaobjetos, un portaobjetos, 2 cubreobjetos y esterilizar a 121 C por 15 min. 2. Colocar sobre el portaobjetos un fragmento de agar papa dextrosa de 1cm Inocular con el asa micológica cada lado del cuadrito de agar con el cultivo del hongo. Colocar encima un cubreobjetos. 4. Colocar a un lado, una torunda de algodón impregnada de glicerol al 10%, estéril; incubar a 28 C durante 48 h.
5 MICROCULTIVO
6 PREPARACIONES TEMPORALES: microcultivo de hongos 5. Eliminar la torunda y agregar dos gotitas de formaldehído g.r. Dejar reposar una hora. 6. En un portaobjetos, colocar una gotita de azul de algodón y colocar el cubreobjetos superior del microcultivo, sellar con esmalte de uñas transparente. Eliminar el agar y colocar otra gotita de azul de algodón, sellar con esmalte. 7. Observar a 10X y 40 X. Realizar dibujos respetando los aumentos y colorearlos.
7 MICROCULTIVO
8 Penicillium sp.
9 Acremonium sp.
10 Preparaciones Fijas Agentes fijadores Agentes físicos.- calor, resinas Agentes químicos: Etanol al 100% Paraformaldehído Gliceraldehído tetróxido de osmio
11 Preparaciones Fijas: Transferir una pequeña porción de la colonia a un portaobjetos limpio y desengrasado, homogeneizar con una gotita de agua. Dejar secar al aire y fijar con calor suave.
12 TINCIONES TINCIONES SIMPLES TINCIONES DIFERENCIALES TINCIONES ESPECÍFICAS
13 Tinción de Gram Colocar una gotita de cristal violeta sobre el frotis, dejar interactuar 1 min. Enjuagar con agua Colocar una gotita de lugol durante 1 min., enjuagar con agua Colocar dos gotitas de etanol-acetona y enjuagar con agua Colocar una gotita de safranina, 30 seg., y enjuagar con agua dejar secar y observar a 10X, 40X y 100X a inmersión. Dibujar y colorear.
14 Cepas aisladas de gasoductos (Tinción de Gram)
15 TINCIÓN CON NARANJA DE ACRIDINA Transferir una gota del cultivo a un portaobjetos limpio y desengrasado, dejar secar al aire. Fijar con etanol al 100%, cubriendo el frotis durante 5 min. Eliminar el etanol y colocar 100 L de naranja de acridina durante 3 min.
16 TINCIÓN CON NARANJA DE ACRIDINA Eliminar el exceso del colorante con etanol al 70%. Observar en un microscopio de epifluorescencia con un filtro azul, emisión a 490 nm.
17 MICROSCOPIA DE EPIFLUORESCENCIA
18 PREPARACIÓN FIJA: SEM Fijar una porción del cultivo con glutaraldehído al 2%, g.m. por 8 h. Eliminar el glutaraldehído lavando 3-4 veces con amortiguador de fosfatos Agregar 2 gotas de tetróxido de osmio y fijar durante 3 h. Lavar con amortiguador de fosfatos Deshidratar con etanol en concentraciones crecientes (40, 50, 60, 70, 90 y 100%) Secar al punto crítico durante 1h Cubrir con carbono y oro en polvo Observar en el microscopio electrónico.
19 Microscopía Electrónica De Barrido (SEM) biopelícula de 10 m de grosor D. alaskensis
20 TINCIÓN DIFERENCIAL TINCIÓN DE ZIEHL-NEELSEN (AAR) Se utiliza para diferenciar las bacterias denominadas ácido alcohol resistentes de las No ácido alcohol resistentes Algunas bacterias poseen, en su pared celular, ciertos ácidos grasos de cadena larga que les confiere la propiedad de resistir la decoloración con alcohol ácido, tras haber sido teñidas con colorantes básicos. Esta tinción requiere un calentamiento para que el colorante atraviese la pared bacteriana que contiene la capa cerosa formada por ácido micólico
21 TINCIÓN DIFERENCIAL TINCIÓN DE ZIEHL-NEELSEN (AAR) Frotis bacteriano Cubrir el frotis con Fucsina fenicada y calentar hasta emisión de vapores durante 5 minutos. Lavar con agua de la llave Decolorar con alcohol ácido 1 minuto (asegurándose de que no se desprende mas color rojo). Lavar con agua de la llave para eliminar el exceso Agregar azul de metileno al 1% como colorante de contraste
22 Mycobacterium sp X Nocardia asteroides, 1000 X Los bacilos ácido alcohol resistentes aparecen coloreados en rojo sobre el fondo azul de la preparación. Este tipo de tinción se utiliza para observar los géneros Mycobacterium y Nocardia Las bacterias No ácido alcohol resistentes se tiñen con el colorante de contraste (azul)
23 Tinciones Estructurales Estructura Flagelos Esporas Cápsula Corpúsculos Gránulos Metacromáticos Método de Fontana-Tribondeau Método de Leifson Método de Moeller Método de Wirtz-Conklin Método de Hiss Tinción Método de la Tinta china Método de Albert Método de Loeffler
24 TINCIÓN DE SCHAEFFER-FULTON Las esporas son formas de resistencia bacteriana. Tienen forma esférica u oval. Al microscopio las esporas sin teñir se observan como gránulos brillantes. Según su localización se distinguen tres tipos de esporas: Centrales, Subterminales, Terminales Realizar el frotis Cubrir el frotis con verde de malaquita Calentar 5 minutos a emisión de vapores Enjuagar con agua de la llave Cubrir con la Safranina dejar actuar 1 minuto lavar con agua de la llave y dejar secar al aire.
25 Endosporas: Técnica Schaeffer y Fulton Bacillus sp X 1250X
26 TINCIÓN DE NEGATIVA DE CAPSULA La cápsula es una capa mucosa, más o menos gruesa, que envuelve la pared celular de algunas bacterias. Esta compuesta de polisacaridos, mucopolisacaridos o polipéptidos Por su alto contenido de agua se tiñen débilmente por los colorantes Prepara un frotis a partir de una suspensión densa de bacterias en solución salina al 0.85% Agregar una gotita de cristal violeta o de tinta china. Dejar secar al aire y observar
PRÁCTICO N 3. Técnicas para la observación, aislamiento y conservación de microorganismos
 PRÁCTICO N 3 Técnicas para la observación, aislamiento y conservación de microorganismos Objetivos Conocer el manejo del microscopio óptico, sus partes y utilidad en el laboratorio de microbiología. Conocer
PRÁCTICO N 3 Técnicas para la observación, aislamiento y conservación de microorganismos Objetivos Conocer el manejo del microscopio óptico, sus partes y utilidad en el laboratorio de microbiología. Conocer
Técnicas de observación de microorganismos
 Fundamentos y técnicas de análisis microbiológicos Técnicas de observación de microorganismos - 1 Técnicas de observación de microorganismos El examen microscópico es el primer paso para el estudio de
Fundamentos y técnicas de análisis microbiológicos Técnicas de observación de microorganismos - 1 Técnicas de observación de microorganismos El examen microscópico es el primer paso para el estudio de
PRACTICA Núm. 3 PREPARACIONES DE EXTENSIONES O FROTIS Y TINCION SIMPLE
 PRACTICA Núm. 3 PREPARACIONES DE EXTENSIONES O FROTIS Y TINCION SIMPLE I. OBJETIVO Conocer el procedimiento para preparar extensiones ó frotis y los diferentes métodos de tinción, así como su utilidad
PRACTICA Núm. 3 PREPARACIONES DE EXTENSIONES O FROTIS Y TINCION SIMPLE I. OBJETIVO Conocer el procedimiento para preparar extensiones ó frotis y los diferentes métodos de tinción, así como su utilidad
AcuaNatura ÍNDICE TÉCNICAS DE TINCIÓN
 TÉCNICAS DE TINCIÓN ÍNDICE 1. Introducción 3 2. Tipos de tinciones 4 2.1. Tinción de Gram 4 2.2. Tinción ácido alcohol resistencia 5 2.3. Tinción de esporas 5 2.4. Tinción negativa 6 3. Precauciones 7
TÉCNICAS DE TINCIÓN ÍNDICE 1. Introducción 3 2. Tipos de tinciones 4 2.1. Tinción de Gram 4 2.2. Tinción ácido alcohol resistencia 5 2.3. Tinción de esporas 5 2.4. Tinción negativa 6 3. Precauciones 7
o Solución de KOH al 0,01% Disolver el colorante en el alcohol, y añadir la solución de KOH
 OBSERVACIÓN DE LAS BACTERIAS TINCIÓN SENCILLA 1.- Material necesario Cultivo bacteriano de 24 horas, en medio sólido Portaobjetos limpios y desengrasados Frasco lavador con agua de grifo o destilada Asa
OBSERVACIÓN DE LAS BACTERIAS TINCIÓN SENCILLA 1.- Material necesario Cultivo bacteriano de 24 horas, en medio sólido Portaobjetos limpios y desengrasados Frasco lavador con agua de grifo o destilada Asa
PRACTICA 2 TINCION DE GRAM
 PRACTICA 2 TINCION DE GRAM OBJETIVOS DE APRENDIZAJE: Cuando haya completado este experimento, usted debe comprender: 1. La base teórica y química de los procedimientos de tinción diferencial. 2. La base
PRACTICA 2 TINCION DE GRAM OBJETIVOS DE APRENDIZAJE: Cuando haya completado este experimento, usted debe comprender: 1. La base teórica y química de los procedimientos de tinción diferencial. 2. La base
Laboratorio de Introducción a la Microbiología. Practico N 1
 Laboratorio de Introducción a la Microbiología Practico N 1 PREPARACIÓN PARA LA OBSERVACIÓN DE MICROORGANISMOS POR MICROSCOPIA Los microorganismos son demasiado pequeños para ser observados a simple vista,
Laboratorio de Introducción a la Microbiología Practico N 1 PREPARACIÓN PARA LA OBSERVACIÓN DE MICROORGANISMOS POR MICROSCOPIA Los microorganismos son demasiado pequeños para ser observados a simple vista,
UNIVERSIDAD AUTONOMA DE CHIAPAS FACULTAD DE CIENCIAS QUIMICAS CAMPUS IV OCOZOCOAUTLA DE ESPINOZA. LABORATORIO DE BIOLOGIA CELULAR
 UNIVERSIDAD AUTONOMA DE CHIAPAS FACULTAD DE CIENCIAS QUIMICAS CAMPUS IV OCOZOCOAUTLA DE ESPINOZA. LABORATORIO DE BIOLOGIA CELULAR Catedrático: Dra. Ana Olivia cañas Urbina. PRACTICA No. 3: TINCIONES Equipo:
UNIVERSIDAD AUTONOMA DE CHIAPAS FACULTAD DE CIENCIAS QUIMICAS CAMPUS IV OCOZOCOAUTLA DE ESPINOZA. LABORATORIO DE BIOLOGIA CELULAR Catedrático: Dra. Ana Olivia cañas Urbina. PRACTICA No. 3: TINCIONES Equipo:
Easy PDF Creator is professional software to create PDF. If you wish to remove this line, buy it now.
 1 Bacteriología Veterinaria. TRABAJO PRÁCTICO No. 1 PRIMER PERIODO MICROSCOPÍA Y MORFOLOGÍA DE BACTERIAS OBJETIVOS 1. Manipular correctamente cada una de las partes del microscopio compuesto de campo claro.
1 Bacteriología Veterinaria. TRABAJO PRÁCTICO No. 1 PRIMER PERIODO MICROSCOPÍA Y MORFOLOGÍA DE BACTERIAS OBJETIVOS 1. Manipular correctamente cada una de las partes del microscopio compuesto de campo claro.
PRACTICA #2 ESTUDIO MICROSCOPICO DE LAS BACTERIAS
 PRACTICA #2 ESTUDIO MICROSCOPICO DE LAS BACTERIAS OBJETIVO DE LA PRACTICA Desarrollar las técnicas microscópicas comunes para observar, teñir y medir a las bacterias y sus estructuras. INTRODUCCION El
PRACTICA #2 ESTUDIO MICROSCOPICO DE LAS BACTERIAS OBJETIVO DE LA PRACTICA Desarrollar las técnicas microscópicas comunes para observar, teñir y medir a las bacterias y sus estructuras. INTRODUCCION El
Protocolos Laboratorio de Microbiología Experimental 2014 PREPARACIONES MICROBIOLÓGICAS
 PREPARACIONES MICROBIOLÓGICAS Objetivos PREPARACIONES HÚMEDAS (EN FRESCO) Al finalizar esta práctica el alumno será capaz de: Realizar diferentes preparaciones microbiológicas a partir de muestras naturales.
PREPARACIONES MICROBIOLÓGICAS Objetivos PREPARACIONES HÚMEDAS (EN FRESCO) Al finalizar esta práctica el alumno será capaz de: Realizar diferentes preparaciones microbiológicas a partir de muestras naturales.
ESTUDIO MICROSCÓPICO DE LAS BACTERIAS DEL YOGUR
 ESTUDIO MICROSCÓPICO DE LAS BACTERIAS DEL YOGUR 1- Prepara un portaobjetos bien limpio con una gota de agua. 2 - Coge una porción pequeña de yogur con un palillo o una aguja enmangada y hacer una extensión
ESTUDIO MICROSCÓPICO DE LAS BACTERIAS DEL YOGUR 1- Prepara un portaobjetos bien limpio con una gota de agua. 2 - Coge una porción pequeña de yogur con un palillo o una aguja enmangada y hacer una extensión
PRÁCTICA 2.2 Preparaciones microbiológicas
 PRÁCTICA 2.2 Preparaciones microbiológicas Objetivos Al finalizar esta práctica el alumno será capaz de: Realizar diferentes preparaciones microbiológicas a partir de muestras naturales y cultivos puros.
PRÁCTICA 2.2 Preparaciones microbiológicas Objetivos Al finalizar esta práctica el alumno será capaz de: Realizar diferentes preparaciones microbiológicas a partir de muestras naturales y cultivos puros.
PRACTICA #5 BIOLOGIA CELULAR VETERINARIA SOLUCIONES HIPERTONICAS E HIPOTONICAS
 PRACTICA #5 BIOLOGIA CELULAR VETERINARIA SOLUCIONES HIPERTONICAS E HIPOTONICAS OBJETIVO: Observar el efecto de las soluciones con diferente concentración de soluto en células sanguíneas. FUNDAMENTO: Todas
PRACTICA #5 BIOLOGIA CELULAR VETERINARIA SOLUCIONES HIPERTONICAS E HIPOTONICAS OBJETIVO: Observar el efecto de las soluciones con diferente concentración de soluto en células sanguíneas. FUNDAMENTO: Todas
UNIVERSIDAD DE MAYORES PRÁCTICAS DE MICROBIOLOGÍA DEPARTAMENTO DE BIOMEDICINA Y BIOTECNOLOGÍA MICROBIOLOGÍA I
 UNIVERSIDAD DE MAYORES PRÁCTICAS DE MICROBIOLOGÍA DEPARTAMENTO DE BIOMEDICINA Y BIOTECNOLOGÍA MICROBIOLOGÍA I DRAS. MARÍA LUISA ORTIZ Y ANA PEDREGOSA 1 PRÁCTICAS DE MICROBIOLOGÍA DEPARTAMENTO DE BIOMEDICINA
UNIVERSIDAD DE MAYORES PRÁCTICAS DE MICROBIOLOGÍA DEPARTAMENTO DE BIOMEDICINA Y BIOTECNOLOGÍA MICROBIOLOGÍA I DRAS. MARÍA LUISA ORTIZ Y ANA PEDREGOSA 1 PRÁCTICAS DE MICROBIOLOGÍA DEPARTAMENTO DE BIOMEDICINA
UNIVERSIDAD TECNOLOGICA NACIONAL
 UNIVERSIDAD TECNOLOGICA NACIONAL FACULTAD REGIONAL ROSARIO DEPARTAMENTO DE INGENIERIA QUIMICA CATEDRA DE BIOTECNOLOGIA Trabajo práctico n 4 Tinción y observación de microorganismos. 2009 Jefe de Cátedra:
UNIVERSIDAD TECNOLOGICA NACIONAL FACULTAD REGIONAL ROSARIO DEPARTAMENTO DE INGENIERIA QUIMICA CATEDRA DE BIOTECNOLOGIA Trabajo práctico n 4 Tinción y observación de microorganismos. 2009 Jefe de Cátedra:
Trabajo práctico Nº 6. Introducción. Ejercicio teórico MORFOLOGÍA Y TINCIÓN DE LOS MICROORGANISMOS. Objetivo. Procedimiento.
 Introducción Ejercicio teórico Objetivo Trabajo práctico Nº 6 MORFOLOGÍA Y TINCIÓN DE LOS MICROORGANISMOS Procedimiento Resultados Actividades adicionales Bibliografía INTRODUCCIÓN Una de las características
Introducción Ejercicio teórico Objetivo Trabajo práctico Nº 6 MORFOLOGÍA Y TINCIÓN DE LOS MICROORGANISMOS Procedimiento Resultados Actividades adicionales Bibliografía INTRODUCCIÓN Una de las características
PROCESAMIENTO DE MUESTRAS VAGINALES
 PROCESAMIENTO DE MUESTRAS VAGINALES Proyecto AECID 2012 Nuevos procedimientos para el diagnóstico de enfermedades olvidadas utilizando tele-microscopía de bajo coste. 1 TABLA DE CONTENIDOS TOMA DE LA MUESTRA
PROCESAMIENTO DE MUESTRAS VAGINALES Proyecto AECID 2012 Nuevos procedimientos para el diagnóstico de enfermedades olvidadas utilizando tele-microscopía de bajo coste. 1 TABLA DE CONTENIDOS TOMA DE LA MUESTRA
TEMA 9. Métodos ópticos para el diagnóstico de laboratorio de enfermedades infecciosas
 TEMA 9 Métodos ópticos para el diagnóstico de laboratorio de enfermedades infecciosas Tema 9. Métodos ópticos para el diagnóstico de laboratorio de enfermedades infecciosas 1. Examen microscópico del material
TEMA 9 Métodos ópticos para el diagnóstico de laboratorio de enfermedades infecciosas Tema 9. Métodos ópticos para el diagnóstico de laboratorio de enfermedades infecciosas 1. Examen microscópico del material
UNIVERSIDAD NACIONAL DE COLOMBIA FACULTAD DE MEDICINA DEPARTAMENTO DE MICROBIOLOGIA PRACTICAS DE LABORATORIO IDENTIFICACION BACTERIANA II
 UNIVERSIDAD NACIONAL DE COLOMBIA FACULTAD DE MEDICINA DEPARTAMENTO DE MICROBIOLOGIA PRACTICAS DE LABORATORIO IDENTIFICACION BACTERIANA II Maye Bernal Rivera PARTE II. LECTURA E INTERPRETACION DE LOS CULTIVOS
UNIVERSIDAD NACIONAL DE COLOMBIA FACULTAD DE MEDICINA DEPARTAMENTO DE MICROBIOLOGIA PRACTICAS DE LABORATORIO IDENTIFICACION BACTERIANA II Maye Bernal Rivera PARTE II. LECTURA E INTERPRETACION DE LOS CULTIVOS
Laboratorio 4: Tinción de microorganismos. Biol 3725L
 Laboratorio 4: Tinción de microorganismos Biol 3725L 1 ml 1 ml Repaso de diluciones 0.1 ml 1 ml 1 ml 9 ml 1 / 10 10-1 99 ml 9.9ml 9 ml 1 / 100 10-3 1 ml 0.1/ 10 1/ 100 10-5 1/10 10-6 1 ml 9 ml 1/10 10-7
Laboratorio 4: Tinción de microorganismos Biol 3725L 1 ml 1 ml Repaso de diluciones 0.1 ml 1 ml 1 ml 9 ml 1 / 10 10-1 99 ml 9.9ml 9 ml 1 / 100 10-3 1 ml 0.1/ 10 1/ 100 10-5 1/10 10-6 1 ml 9 ml 1/10 10-7
Microscopio y observación de células
 I.E.S. Rayuela - Departamento de Biología y Geología Práctica nº1 de Anatomía Aplicada Microscopio y observación de células Las células suelen ser de tamaño muy pequeño de modo que permanecen invisibles
I.E.S. Rayuela - Departamento de Biología y Geología Práctica nº1 de Anatomía Aplicada Microscopio y observación de células Las células suelen ser de tamaño muy pequeño de modo que permanecen invisibles
LABORATORIO DE MICROBIOLOGÍA EXPERIMENTAL Grupo 2 (10:00 13:00 hrs) Semestre Profesores: Guadalupe Tsuzuki Reyes y Rosalba Esquivel-Cote
 Semana 2 Semana 1 LABORATORIO DE EXPERIMENTAL Grupo 2 (10:00 13:00 hrs) Semestre 2013-2 Profesores: Guadalupe Tsuzuki Reyes y Rosalba Esquivel-Cote CALENDARIO DE ACTIVIDADES UNIDAD Lunes 28 ENERO Miércoles
Semana 2 Semana 1 LABORATORIO DE EXPERIMENTAL Grupo 2 (10:00 13:00 hrs) Semestre 2013-2 Profesores: Guadalupe Tsuzuki Reyes y Rosalba Esquivel-Cote CALENDARIO DE ACTIVIDADES UNIDAD Lunes 28 ENERO Miércoles
Trabajo Práctico N 6. MICROBIOLOGÍA (Octubre 2012) Claudia Herrmann [email protected]
 MICROSCOPÍA Trabajo Práctico N 6 MICROBIOLOGÍA (Octubre 2012) Claudia Herrmann [email protected] 1 MICROSCOPÍA Microscopio Óptico Campo claro Campo oscuro Contraste de fase Fluorescencia Confocal
MICROSCOPÍA Trabajo Práctico N 6 MICROBIOLOGÍA (Octubre 2012) Claudia Herrmann [email protected] 1 MICROSCOPÍA Microscopio Óptico Campo claro Campo oscuro Contraste de fase Fluorescencia Confocal
Objetivos. S Determinar la presencia de bacterias coliformes en una muestra de agua
 Análisis del agua S Objetivos S Determinar la presencia de bacterias coliformes en una muestra de agua Introducción S Las tres pruebas básicas para determinar la presencia de bacterias coliformes (asociada
Análisis del agua S Objetivos S Determinar la presencia de bacterias coliformes en una muestra de agua Introducción S Las tres pruebas básicas para determinar la presencia de bacterias coliformes (asociada
Práctica 3: Identificación de Componentes de la Pared Celular Vegetal
 Práctica 3: Identificación de Componentes de la Pared Celular Vegetal Práctica 3 Contenidos teóricos La pared celular Modificaciones Desarrollo práctico La Pared Celular Citosol Pared celular Pared celular
Práctica 3: Identificación de Componentes de la Pared Celular Vegetal Práctica 3 Contenidos teóricos La pared celular Modificaciones Desarrollo práctico La Pared Celular Citosol Pared celular Pared celular
MICROBIOLOGÍA E INMUNOLOGÍA PARTE A LIC. en BIOLOGÍA MOLECULAR. EXPLICACIÓN DE TRABAJO PRÁCTICO N 2 COLORACIONES I y II
 MICROBIOLOGÍA E INMUNOLOGÍA PARTE A LIC. en BIOLOGÍA MOLECULAR EXPLICACIÓN DE TRABAJO PRÁCTICO N 2 COLORACIONES I y II 1. Forma o morfología de las bacterias Las bacterias tienen tamaños y formas muy variables.
MICROBIOLOGÍA E INMUNOLOGÍA PARTE A LIC. en BIOLOGÍA MOLECULAR EXPLICACIÓN DE TRABAJO PRÁCTICO N 2 COLORACIONES I y II 1. Forma o morfología de las bacterias Las bacterias tienen tamaños y formas muy variables.
PRÁCTICA No. 4 Métodos de cultivo y descripción morfológica de hongos Introducción
PRÁCTICA No. 4 Métodos de cultivo y descripción morfológica de hongos Objetivos. Que el alumno aprenda las técnicas de cultivo y manipulación de diferentes tipos de hongos. Que el estudiante conozca las
PRÁCTICA No. 4 Métodos de cultivo y descripción morfológica de hongos Objetivos. Que el alumno aprenda las técnicas de cultivo y manipulación de diferentes tipos de hongos. Que el estudiante conozca las
RECONOCIMIENTO DE LOS PRINCIPIOS INMEDIATOS QUE HAY EN UN ALIMENTO
 RECONOCIMIENTO DE LOS PRINCIPIOS INMEDIATOS QUE HAY EN UN ALIMENTO Fundamento Los alimentos se diferencian entre sí por las sustancias o principios inmediatos que contienen y por la cantidad de cada uno
RECONOCIMIENTO DE LOS PRINCIPIOS INMEDIATOS QUE HAY EN UN ALIMENTO Fundamento Los alimentos se diferencian entre sí por las sustancias o principios inmediatos que contienen y por la cantidad de cada uno
UNIVERSIDAD DE GUADALAJARA CENTRO UNIVERSITARIO DE LOS LAGOS INGENIERÍA EN BIOQUÍMICA BOTÁNICA 2014B DRA. EN C. SOFÍA LOZA CORNEJO
 UNIVERSIDAD DE GUADALAJARA CENTRO UNIVERSITARIO DE LOS LAGOS INGENIERÍA EN BIOQUÍMICA BOTÁNICA 2014B DRA. EN C. SOFÍA LOZA CORNEJO PRÁCTICA 4. TEJIDOS VEGETALES. II. TEJIDO FUNDAMENTAL (PARÉNQUIMA, COLÉNQUIMA
UNIVERSIDAD DE GUADALAJARA CENTRO UNIVERSITARIO DE LOS LAGOS INGENIERÍA EN BIOQUÍMICA BOTÁNICA 2014B DRA. EN C. SOFÍA LOZA CORNEJO PRÁCTICA 4. TEJIDOS VEGETALES. II. TEJIDO FUNDAMENTAL (PARÉNQUIMA, COLÉNQUIMA
GUIA II DE LABORATORIO I. REINOS DE LA NATURALEZA
 1 UNIVERSIDAD NACIONAL ABIERTA Y A DISTANCIA UNAD ESCUELA DE CIENCIAS BASICAS, TECNOLOGIA E INGENIERIA CURSO DE BIOLOGIA TUTORA: YAMILE CORTES [email protected] labbiologiayamilecortesunad.wordpress.com
1 UNIVERSIDAD NACIONAL ABIERTA Y A DISTANCIA UNAD ESCUELA DE CIENCIAS BASICAS, TECNOLOGIA E INGENIERIA CURSO DE BIOLOGIA TUTORA: YAMILE CORTES [email protected] labbiologiayamilecortesunad.wordpress.com
TRABAJO PRÁCTICO N 3: Identificación microbiana
 TRABAJO PRÁCTICO N 3: Identificación microbiana PARTE A: Identificación Fenotípica 1.-Pruebas Bioquímicas 2- Coloraciones 3. Uso del Manual Bergey Pruebas Bioquímicas Son una serie de pruebas que permiten
TRABAJO PRÁCTICO N 3: Identificación microbiana PARTE A: Identificación Fenotípica 1.-Pruebas Bioquímicas 2- Coloraciones 3. Uso del Manual Bergey Pruebas Bioquímicas Son una serie de pruebas que permiten
TRABAJO PRÁCTICO Nº 3. Parte A: Examen macroscópico de los microorganismos.
 TRABAJO PRÁCTICO Nº 3 Parte A: Examen macroscópico de los microorganismos. OBJETIVOS - Caracterizar el desarrollo macroscópico de los microorganismos en medios de cultivo líquidos y sólidos - Adquirir
TRABAJO PRÁCTICO Nº 3 Parte A: Examen macroscópico de los microorganismos. OBJETIVOS - Caracterizar el desarrollo macroscópico de los microorganismos en medios de cultivo líquidos y sólidos - Adquirir
Técnicas de monitoreo para la detección de microorganismos en el medio ambiente
 Técnicas de monitoreo para la detección de microorganismos en el medio ambiente Gloria Alicia Figueroa Aguilar Condiciones Ambientales REQUISITO: El laboratorio debe asegurarse que las condiciones ambientales,
Técnicas de monitoreo para la detección de microorganismos en el medio ambiente Gloria Alicia Figueroa Aguilar Condiciones Ambientales REQUISITO: El laboratorio debe asegurarse que las condiciones ambientales,
PRÁCTICA 5. TEJIDOS VEGETALES III. TEJIDO EPIDÉRMICO Y PERIDÉRMICO.
 UNIVERSIDAD DE GUADALAJARA CENTRO UNIVERSITARIO DE LOS LAGOS INGENIERÍA EN BIOQUÍMICA MATERIA: BOTÁNICA SEMESTRE: 2014B PROF. DRA. EN C. SOFÍA LOZA CORNEJO PRÁCTICA 5. TEJIDOS VEGETALES III. TEJIDO EPIDÉRMICO
UNIVERSIDAD DE GUADALAJARA CENTRO UNIVERSITARIO DE LOS LAGOS INGENIERÍA EN BIOQUÍMICA MATERIA: BOTÁNICA SEMESTRE: 2014B PROF. DRA. EN C. SOFÍA LOZA CORNEJO PRÁCTICA 5. TEJIDOS VEGETALES III. TEJIDO EPIDÉRMICO
2. Observación de hongos de interés industrial
 2. Observación de hongos de interés industrial En esta práctica se realizarán observaciones en fresco de varios hongos de interés industrial. 2.1 Preparaciones para el estudio microscópico de los aislados
2. Observación de hongos de interés industrial En esta práctica se realizarán observaciones en fresco de varios hongos de interés industrial. 2.1 Preparaciones para el estudio microscópico de los aislados
LOS MICROORGANISMOS EN EL AMBIENTE
 Introducción Objetivo Fundamento Trabajo Práctico Nº 2 LOS MICROORGANISMOS EN EL AMBIENTE Procedimiento Resultados Observaciones Conclusiones INTRODUCCIÓN La microbiología es la ciencia que estudia los
Introducción Objetivo Fundamento Trabajo Práctico Nº 2 LOS MICROORGANISMOS EN EL AMBIENTE Procedimiento Resultados Observaciones Conclusiones INTRODUCCIÓN La microbiología es la ciencia que estudia los
Agentes desinfectantes objetos inertes. Agentes antisépticos tejidos vivos
 Agentes desinfectantes son agentes químicos capaces de matar los microorganismos patógenos de un material. Pueden presentar efectos tóxicos sobre tejidos vivos, por lo que se suelen usar sólo en objetos
Agentes desinfectantes son agentes químicos capaces de matar los microorganismos patógenos de un material. Pueden presentar efectos tóxicos sobre tejidos vivos, por lo que se suelen usar sólo en objetos
Técnicas de tinción. Fundamentos
 Técnicas de tinción. Fundamentos El tamaño de la mayoría de las células bacterianas es tal que resultan difíciles de ver con el microscopio óptico. La principal dificultad es la falta de contraste entre
Técnicas de tinción. Fundamentos El tamaño de la mayoría de las células bacterianas es tal que resultan difíciles de ver con el microscopio óptico. La principal dificultad es la falta de contraste entre
Easy PDF Creator is professional software to create PDF. If you wish to remove this line, buy it now.
 1 Unidad Curricular: Virología y Micología Veterinaria TRABAJO PRÁCTICO No. 6 MICOLOGÍA OBJETIVO 1. Estudiar las características morfológicas de los hongos y su crecimiento en los medios de cultivo. GENERALIDADES
1 Unidad Curricular: Virología y Micología Veterinaria TRABAJO PRÁCTICO No. 6 MICOLOGÍA OBJETIVO 1. Estudiar las características morfológicas de los hongos y su crecimiento en los medios de cultivo. GENERALIDADES
COLORACION o TINCION DE GRAM?
 Artículo escrito por: COLORACION o TINCION DE GRAM? Lic. TM Yvan V. Salazar Criado Lic TM Julia M. Neciosup Zapata INTRODUCCION La rápida evolución tecnológica está transformando el Mundo en que vivimos,
Artículo escrito por: COLORACION o TINCION DE GRAM? Lic. TM Yvan V. Salazar Criado Lic TM Julia M. Neciosup Zapata INTRODUCCION La rápida evolución tecnológica está transformando el Mundo en que vivimos,
LABORATORIO No.3 OBSERVACIÓN DE CÉLULAS VEGETALES Y DIFERENCIACIONES CITOPLASMATICAS
 LABORATORIO No.3 OBSERVACIÓN DE CÉLULAS VEGETALES Y DIFERENCIACIONES CITOPLASMATICAS INTRODUCCIÓN En el universo biológico se encuentran dos tipos de células: procariotas y eucariotas. Estas últimas a
LABORATORIO No.3 OBSERVACIÓN DE CÉLULAS VEGETALES Y DIFERENCIACIONES CITOPLASMATICAS INTRODUCCIÓN En el universo biológico se encuentran dos tipos de células: procariotas y eucariotas. Estas últimas a
COLEGIO DE BACHILLERES DEL ESTADO DE TLAXCALA DIRECCIÓN ACADÉMICA DEPARTAMENTO DE BIBLIOTECAS Y LABORATORIOS BIOLOGÍA I ACTIVIDAD EXPERIMENTAL NUM
 DIRECCIÓN ACADÉMICA DEPARTAMENTO DE BIBLIOTECAS Y LABORATORIOS BIOLOGÍA I ACTIVIDAD EXPERIMENTAL NUM. 2 ESTRUCTURA CELULAR (BLOLQUE III) INTRODUCCIÓN La célula es la unidad anatómica y fisiológica de los
DIRECCIÓN ACADÉMICA DEPARTAMENTO DE BIBLIOTECAS Y LABORATORIOS BIOLOGÍA I ACTIVIDAD EXPERIMENTAL NUM. 2 ESTRUCTURA CELULAR (BLOLQUE III) INTRODUCCIÓN La célula es la unidad anatómica y fisiológica de los
1. CARACTERÍSTICAS DIFERENCIALES DE BACTERIAS, HONGOS, PARÁSITOS Y VIRUS.
 TEMA 20: MICROBIOLOGÍA CLÍNICA: CARACTERÍSTICAS DIFERENCIALES DE BACTERIAS, HONGOS, PARÁSITOS Y VIRUS. TÉCNICAS DE OBSERVACIÓN. TIPOS DE TINCIONES. El laboratorio de Microbiología Clínica desempeña un
TEMA 20: MICROBIOLOGÍA CLÍNICA: CARACTERÍSTICAS DIFERENCIALES DE BACTERIAS, HONGOS, PARÁSITOS Y VIRUS. TÉCNICAS DE OBSERVACIÓN. TIPOS DE TINCIONES. El laboratorio de Microbiología Clínica desempeña un
UNIVERSIDAD AUTÓNOMA DE NUEVO LEÓN FACULTAD DE CIENCIAS QUÍMICAS QUÍMICO FARMACÉUTICO BIÓLOGO
 UNIVERSIDAD AUTÓNOMA DE NUEVO LEÓN FACULTAD DE CIENCIAS QUÍMICAS QUÍMICO FARMACÉUTICO BIÓLOGO Practica Nº 1 Morfología Celular In Vivo E In Vitro Biología Celular Dr. Isaías Balderas Renteria Esther Baltazar
UNIVERSIDAD AUTÓNOMA DE NUEVO LEÓN FACULTAD DE CIENCIAS QUÍMICAS QUÍMICO FARMACÉUTICO BIÓLOGO Practica Nº 1 Morfología Celular In Vivo E In Vitro Biología Celular Dr. Isaías Balderas Renteria Esther Baltazar
Estructura y Morfología bacteriana 6:41
 Estructura y Morfología bacteriana PROFESOR: JOSÉ AMARO SUAZO Generalidades estructurales Bacteria: bacterium = bastón Características Ribosoma 70S Pared bacteriana Ausencia de esteroles Ausencia de mitocondrias,
Estructura y Morfología bacteriana PROFESOR: JOSÉ AMARO SUAZO Generalidades estructurales Bacteria: bacterium = bastón Características Ribosoma 70S Pared bacteriana Ausencia de esteroles Ausencia de mitocondrias,
Dr. Oscar Gutiérrez Coronado Microbiologia Práctica No. 1 Preparación y esterilización de materiales y medios de cultivo
 Dr. Oscar Gutiérrez Coronado Microbiologia Práctica No. 1 Preparación y esterilización de materiales y medios de cultivo Objetivos. Que el alumno conozca los principios generales de las técnicas de esterilización
Dr. Oscar Gutiérrez Coronado Microbiologia Práctica No. 1 Preparación y esterilización de materiales y medios de cultivo Objetivos. Que el alumno conozca los principios generales de las técnicas de esterilización
MEDIOS DE CULTIVO Y TINCIÓN DE GRAM
 MEDIOS DE CULTIVO Y TINCIÓN DE GRAM AUTORIA AZAHARA CABRERA ORTEGA TEMÁTICA PRÁCTICAS ETAPA EDUCACIÓN SECUNDARIA POSTOBLIGATORIA Resumen Tanto los medios de cultivo como la realización de tinciones de
MEDIOS DE CULTIVO Y TINCIÓN DE GRAM AUTORIA AZAHARA CABRERA ORTEGA TEMÁTICA PRÁCTICAS ETAPA EDUCACIÓN SECUNDARIA POSTOBLIGATORIA Resumen Tanto los medios de cultivo como la realización de tinciones de
MARCO TEÓRICO. Título: Célula: estructura función. Diversidad celular. Docente: Rolando Hernández Lazo
 Título: Célula: estructura función. Diversidad celular. Docente: Rolando Hernández Lazo OBJETIVOS Al final de esta práctica el estudiante deberá comprobar que: Las células vegetales como las animales poseen
Título: Célula: estructura función. Diversidad celular. Docente: Rolando Hernández Lazo OBJETIVOS Al final de esta práctica el estudiante deberá comprobar que: Las células vegetales como las animales poseen
Barriga Mejia Brenda Paloma López Alavez Ana Maria Martinez Romero Jorge Manuel Grupo: 2405 BACTERIAS
 Barriga Mejia Brenda Paloma López Alavez Ana Maria Martinez Romero Jorge Manuel Grupo: 2405 BACTERIAS Bacterias Las bacterias son microorganismos procariotas que pertenecen al reino monera. Presentan un
Barriga Mejia Brenda Paloma López Alavez Ana Maria Martinez Romero Jorge Manuel Grupo: 2405 BACTERIAS Bacterias Las bacterias son microorganismos procariotas que pertenecen al reino monera. Presentan un
UNIVERSIDAD NACIONAL ABIERTA Y A DISTANCIA UNAD
 UNIVERSIDAD NACIONAL ABIERTA Y A DISTANCIA UNAD ESCUELA DE CIENCIAS BASICAS, TECNOLOGIA E INGENIERIA CURSO DE BIOLOGIA TUTORA: [email protected] labbiologiayamilecortesunad.wordpress.com OBJETIVOS:
UNIVERSIDAD NACIONAL ABIERTA Y A DISTANCIA UNAD ESCUELA DE CIENCIAS BASICAS, TECNOLOGIA E INGENIERIA CURSO DE BIOLOGIA TUTORA: [email protected] labbiologiayamilecortesunad.wordpress.com OBJETIVOS:
PROCEDIMIENTO DETECCIÓN Y ENUMERACIÓN POR NUMERO MAS PROBABLE (NMP) CON ETAPA DE PRE- ENRIQUECIMIENTO DE ENTEROBACTERIACEAE EN ALIMENTOS
 Página 1 de 5 1. OBJETIVO Estimar el número de Enterobacteriaceae presentes en el alimento. 2. CAMPO DE APLICACIÓN Y ALCANCE Aplicar este procedimiento a todas las muestras de alimentos de consumo humano
Página 1 de 5 1. OBJETIVO Estimar el número de Enterobacteriaceae presentes en el alimento. 2. CAMPO DE APLICACIÓN Y ALCANCE Aplicar este procedimiento a todas las muestras de alimentos de consumo humano
TALLER No 1 MAPA CONCEPTUAL DE LA CÉLULA
 TALLER No 1 MAPA CONCEPTUAL DE LA CÉLULA 1. COMPLETE EL MAPA CONCEPTUAL. FUNCIONES: NUCLEO CROMOSOMAS NUCLEOLOS ESTRUCTURA LA CELULA MEMBRANA CELULAR FUNCIONES: FUNCIONES MITOCONDRIAS: RIBOSOMAS: CITOPLASMA
TALLER No 1 MAPA CONCEPTUAL DE LA CÉLULA 1. COMPLETE EL MAPA CONCEPTUAL. FUNCIONES: NUCLEO CROMOSOMAS NUCLEOLOS ESTRUCTURA LA CELULA MEMBRANA CELULAR FUNCIONES: FUNCIONES MITOCONDRIAS: RIBOSOMAS: CITOPLASMA
Familia Mycobacteriaceae
 Familia Mycobacteriaceae En esta Familia está incluido el Género Mycobacterium dentro del cual pueden mencionarse las especies M. tuberculosis, M. bovis, M. leprae y otras consideradas micobacterias atípicas
Familia Mycobacteriaceae En esta Familia está incluido el Género Mycobacterium dentro del cual pueden mencionarse las especies M. tuberculosis, M. bovis, M. leprae y otras consideradas micobacterias atípicas
INSTITUTO CULTURAL TAMPICO COORDINACIÓN LABORATORIOS DE CIENCIAS
 REACTIVO GRADO DE REACTIVIDAD EXISTENCIA 1 Aceite de inmersión Tipo B para microscopia 0 180 ml 2 Acetato de magnesio 0 410 g 3 Acetato de sodio 0 880 g 4 Ácido Cítrico anhidro 0 45 g 5 Ácido oxálico 0
REACTIVO GRADO DE REACTIVIDAD EXISTENCIA 1 Aceite de inmersión Tipo B para microscopia 0 180 ml 2 Acetato de magnesio 0 410 g 3 Acetato de sodio 0 880 g 4 Ácido Cítrico anhidro 0 45 g 5 Ácido oxálico 0
Prácticas: Configuración de los seres vivos. Curso académico Práctica 2. Preparación de extensiones celulares.
 Prácticas: Configuración de los seres vivos. Curso académico 2009-2010 16 Práctica 2. Preparación de extensiones celulares Introducción Se entiende por extensión o frotis celular, a la formación de una
Prácticas: Configuración de los seres vivos. Curso académico 2009-2010 16 Práctica 2. Preparación de extensiones celulares Introducción Se entiende por extensión o frotis celular, a la formación de una
CARRERA DE MEDICINA GUÍA DE PRÁCTICA DE LABORATORIO
 ASIGNATURA: BIOLOGÍA CELULAR Y GENÉTICA CICLO: PRIMERO SEMESTRE: A 2014 ÁREA: CIENCIAS MORFOFUNCIONALES MALLA: 6 NÚMERO HORAS SEMANALES DE LA PRÁCTICA: 2 NIVEL CURRICULAR: BÁSICO (CIENCIAS BÁSICAS) LABORATORIO:
ASIGNATURA: BIOLOGÍA CELULAR Y GENÉTICA CICLO: PRIMERO SEMESTRE: A 2014 ÁREA: CIENCIAS MORFOFUNCIONALES MALLA: 6 NÚMERO HORAS SEMANALES DE LA PRÁCTICA: 2 NIVEL CURRICULAR: BÁSICO (CIENCIAS BÁSICAS) LABORATORIO:
EXAMEN EN FRESCO DE HECES Y PRESENCIA DE HUEVOS PRACTICA 3
 EXAMEN EN FRESCO DE HECES Y PRESENCIA DE HUEVOS PRACTICA 3 1. Introducción Examen macroscópico Es importante determinar la consistencia de las heces fecales y clasificarlas en líquidas, blandas o duras,
EXAMEN EN FRESCO DE HECES Y PRESENCIA DE HUEVOS PRACTICA 3 1. Introducción Examen macroscópico Es importante determinar la consistencia de las heces fecales y clasificarlas en líquidas, blandas o duras,
1. LEVINE EMB AGAR FOTO 6. Medios de cultivo Levine EMG Agar.
 1. LEVINE EMB AGAR. El Agar EMB Levine es un medio selectivo y diferencial, adecuado para el crecimiento de Enterobacterias. Es un medio adecuado para la búsqueda y diferenciación de bacilos entéricos,
1. LEVINE EMB AGAR. El Agar EMB Levine es un medio selectivo y diferencial, adecuado para el crecimiento de Enterobacterias. Es un medio adecuado para la búsqueda y diferenciación de bacilos entéricos,
INSTITUTO POLITÉCNICO NACIONAL
 INSTITUTO POLITÉCNICO NACIONAL UNIDAD PROFESIONAL DE BIOTECNOLOGÍA DEPARTAMENTO DE BIOLOGÍA ACADEMIAA DE MICROBIOLOGÍA MANUAL DE PRÁCTICAS PARA LA ASIGNATURA: LABORATORIO DE TÉCNICAS MICROBIOLÓGICAS PRIMERA
INSTITUTO POLITÉCNICO NACIONAL UNIDAD PROFESIONAL DE BIOTECNOLOGÍA DEPARTAMENTO DE BIOLOGÍA ACADEMIAA DE MICROBIOLOGÍA MANUAL DE PRÁCTICAS PARA LA ASIGNATURA: LABORATORIO DE TÉCNICAS MICROBIOLÓGICAS PRIMERA
Trabajo Práctico N o 2 :Procariotas y Eucariotas. Nombre:... Comisión:...
 Trabajo Práctico N o 2: Trabajo Práctico N o 2 :Procariotas y Eucariotas Procariotas y Eucariotas Nombre:... Comisión:... Objetivos 1. Reconocer tipos celulares en el microscopio. 2. Establecer diferencias
Trabajo Práctico N o 2: Trabajo Práctico N o 2 :Procariotas y Eucariotas Procariotas y Eucariotas Nombre:... Comisión:... Objetivos 1. Reconocer tipos celulares en el microscopio. 2. Establecer diferencias
FACULTAD DE SALUD PROGRAMA DE ENFERMERIA Práctica 11. OBSERVACIÓN DE HONGOS - LEVADURAS
 FACULTAD DE SALUD PROGRAMA DE ENFERMERIA Práctica 11. OBSERVACIÓN DE HONGOS - LEVADURAS Leidy Diana Ardila Leal Docente INTRODUCCIÓN En esta práctica se va a realizar la observación de los hongos, el cual
FACULTAD DE SALUD PROGRAMA DE ENFERMERIA Práctica 11. OBSERVACIÓN DE HONGOS - LEVADURAS Leidy Diana Ardila Leal Docente INTRODUCCIÓN En esta práctica se va a realizar la observación de los hongos, el cual
TRABAJO PRÁCTICO N 2: TÉCNICAS DE ESTERILIZACIÓN Y CULTIVO DE MICROORGANISMOS Objetivos:
 TRABAJO PRÁCTICO N 2: TÉCNICAS DE ESTERILIZACIÓN Y CULTIVO DE MICROORGANISMOS Objetivos: -Conocer las metodologías actuales de control y eliminación de microorganismos. -Obtener dominio de los métodos
TRABAJO PRÁCTICO N 2: TÉCNICAS DE ESTERILIZACIÓN Y CULTIVO DE MICROORGANISMOS Objetivos: -Conocer las metodologías actuales de control y eliminación de microorganismos. -Obtener dominio de los métodos
Técnicas básicas de Microbiología Observación de bacterias
 Técnicas básicas de Microbiología Observación de bacterias Covadonga Vázquez. Ana Martín. Mª Isabel de Silóniz. Susana Serrano. Departamento de Microbiología III. Facultad de Ciencias Biológicas. Universidad
Técnicas básicas de Microbiología Observación de bacterias Covadonga Vázquez. Ana Martín. Mª Isabel de Silóniz. Susana Serrano. Departamento de Microbiología III. Facultad de Ciencias Biológicas. Universidad
PROCESAMIENTO DE MUESTRAS SANGUÍNEAS PARA
 PROCESAMIENTO DE MUESTRAS SANGUÍNEAS PARA DIAGNÓSTICO Proyecto AECID 2012 Nuevos procedimientos para el diagnóstico de enfermedades olvidadas utilizando tele-microscopía de bajo coste. 1 TABLA DE CONTENIDOS
PROCESAMIENTO DE MUESTRAS SANGUÍNEAS PARA DIAGNÓSTICO Proyecto AECID 2012 Nuevos procedimientos para el diagnóstico de enfermedades olvidadas utilizando tele-microscopía de bajo coste. 1 TABLA DE CONTENIDOS
UNIVERSIDAD NACIONAL DEL NORDESTE Facultad de Ciencias Exactas y Naturales y Agrimensura Departamento de Biología - Área Zoología EMBRIOLOGÍA ANIMAL
 UNIVERSIDAD NACIONAL DEL NORDESTE Facultad de Ciencias Exactas y Naturales y Agrimensura Departamento de Biología - Área Zoología EMBRIOLOGÍA ANIMAL PROTOCOLO PARA OBTENCIÓN DE EMBRIONES DE POLLO EN LABORATORIO
UNIVERSIDAD NACIONAL DEL NORDESTE Facultad de Ciencias Exactas y Naturales y Agrimensura Departamento de Biología - Área Zoología EMBRIOLOGÍA ANIMAL PROTOCOLO PARA OBTENCIÓN DE EMBRIONES DE POLLO EN LABORATORIO
o c Insertos Tinciones Hematológicas www.comacmexico.com 01 (55) 2163 4127 Lerdo # 30 Cuajimalpa México, D.F 05000 TINCIÓN DE WRIGHT WRIGHT BUFFER
 c ma o c TINCIÓN DE WRIGHT WRIGHT BUFFER ANTES DE USAR: a) Dejar madurar el colorante de Wright 5 días después de su elaboración. Insertos Tinciones Hematológicas. Colocar el frotis perfectamente seco
c ma o c TINCIÓN DE WRIGHT WRIGHT BUFFER ANTES DE USAR: a) Dejar madurar el colorante de Wright 5 días después de su elaboración. Insertos Tinciones Hematológicas. Colocar el frotis perfectamente seco
V Olimpiada Española de Biología: Fase Nacional
 Código de Identificación 4 últimos dígitos- letra DNI V Olimpiada Española de Biología: Fase Nacional PRÁCTICA 3: IDENTIFICACIÓN DE POLEN Y SUS RELACIONES CON DISTINTOS TIPOS DE POLINIZACIÓN. USO DEL MICROSCOPIO
Código de Identificación 4 últimos dígitos- letra DNI V Olimpiada Española de Biología: Fase Nacional PRÁCTICA 3: IDENTIFICACIÓN DE POLEN Y SUS RELACIONES CON DISTINTOS TIPOS DE POLINIZACIÓN. USO DEL MICROSCOPIO
Trabajo Práctico Nº 8 SANGRE
 Trabajo Práctico Nº 8 SANGRE Este tejido conectivo líquido se estudia mediante los frotis sanguíneos. Estos consisten en la colocación de una gota de sangre sobre el portaobjetos que será extendida con
Trabajo Práctico Nº 8 SANGRE Este tejido conectivo líquido se estudia mediante los frotis sanguíneos. Estos consisten en la colocación de una gota de sangre sobre el portaobjetos que será extendida con
ORGANOS, CELULAS y ATOMOS
 ORGANOS, CELULAS y ATOMOS TAMAÑO DE CÉLULAS, SUS COMPONENTES Y PODER DE RESOLUCIÓN DE LOS MICROSCOPIOS Principios del MICROSCOPIO OPTICO SISTEMA OPTICO DE UN MICROSCOPIO DE FLUORESCENCIA COLORANTES FLUORESCENTES
ORGANOS, CELULAS y ATOMOS TAMAÑO DE CÉLULAS, SUS COMPONENTES Y PODER DE RESOLUCIÓN DE LOS MICROSCOPIOS Principios del MICROSCOPIO OPTICO SISTEMA OPTICO DE UN MICROSCOPIO DE FLUORESCENCIA COLORANTES FLUORESCENTES
IDENTIFICACION DE ORGANELOS CELULARES
 IDENTIFICACION DE ORGANELOS CELULARES Practica de laboratorio de biología celular Dra. Ana Olivia cañas Urbina Integrantes Andrea Pérez Ochoa Diana Laura Vázquez Vázquez Blanca Guadalupe Penagos Gómez
IDENTIFICACION DE ORGANELOS CELULARES Practica de laboratorio de biología celular Dra. Ana Olivia cañas Urbina Integrantes Andrea Pérez Ochoa Diana Laura Vázquez Vázquez Blanca Guadalupe Penagos Gómez
PROCEDIMIENTO RECUENTO DE LACTOBACILLUS BULGARICUS Y STREPTOCOCCUS THERMOPHILUS EN YOGURT. APHA 17 Edición, modificado. PRT-712.02-047 Página 1 de 8
 PRT-712.02-047 Página 1 de 8 1. OBJETIVO Conocer el número de Lactobacillus bulgaricus y Streptococcus thermophilus (microorganismos característicos del yogurt) presentes en una muestra de yogurt. 2. CAMPO
PRT-712.02-047 Página 1 de 8 1. OBJETIVO Conocer el número de Lactobacillus bulgaricus y Streptococcus thermophilus (microorganismos característicos del yogurt) presentes en una muestra de yogurt. 2. CAMPO
PRACTICA Nº 6 GLUCÓSIDOS CARDIOTÓNICOS Y SAPONINAS
 PRACTICA Nº 6 GLUCÓSIDOS CARDIOTÓNICOS Y SAPONINAS GLICÓSIDOS CARDIOTÓNICOS La valoración de glicósidos se puede realizar por los siguientes métodos: Por pesada directa del glicósido aislado, Por colorimetría,
PRACTICA Nº 6 GLUCÓSIDOS CARDIOTÓNICOS Y SAPONINAS GLICÓSIDOS CARDIOTÓNICOS La valoración de glicósidos se puede realizar por los siguientes métodos: Por pesada directa del glicósido aislado, Por colorimetría,
Escuela Universitaria de Ciencias de la Salud. PRÁCTICAS MICROBIOLOGÍA y SALUD PÚBLICA.
 Escuela Universitaria de Ciencias de la Salud PRÁCTICAS MICROBIOLOGÍA y SALUD PÚBLICA. DIAGNÓSTICO DE LAS ENFERMEDADES INFECCIOSAS Día 1: Día 2: Recogida de muestras. Medios de cultivo. Tipos de Siembra
Escuela Universitaria de Ciencias de la Salud PRÁCTICAS MICROBIOLOGÍA y SALUD PÚBLICA. DIAGNÓSTICO DE LAS ENFERMEDADES INFECCIOSAS Día 1: Día 2: Recogida de muestras. Medios de cultivo. Tipos de Siembra
TRABAJO PRÁCTICO Nº 2 CÉLULA Y MATERIAL ÓPTICO
 TRABAJO PRÁCTICO Nº 2 CÉLULA Y MATERIAL ÓPTICO OBJETIVOS: Alumno:.... - Analizar las características y el funcionamiento del instrumental óptico. - Aprender las normas básicas para el cuidado, manejo y
TRABAJO PRÁCTICO Nº 2 CÉLULA Y MATERIAL ÓPTICO OBJETIVOS: Alumno:.... - Analizar las características y el funcionamiento del instrumental óptico. - Aprender las normas básicas para el cuidado, manejo y
2. PREPARACION DE MATERIAL BOTÁNICO PARA SU ESTUDIO ANATÓMICO Y MORFOLÓGICO
 2. PREPARACION DE MATERIAL BOTÁNICO PARA SU ESTUDIO ANATÓMICO Y MORFOLÓGICO OBJETIVOS: 1.- Preparar material vegetal para su observación al microscopio óptico. 2.- Conocer los instrumentos y los métodos
2. PREPARACION DE MATERIAL BOTÁNICO PARA SU ESTUDIO ANATÓMICO Y MORFOLÓGICO OBJETIVOS: 1.- Preparar material vegetal para su observación al microscopio óptico. 2.- Conocer los instrumentos y los métodos
Células. Tema 13 de Biología NS Diploma BI Curso
 Células procariotas 2ª Parte: Células Tema 13 de Biología NS Diploma BI Curso 2013-2015 Diversidad del dominio Eubacteria Grupo muy amplio de bacterias que, debido a su gran variedad genética, participan
Células procariotas 2ª Parte: Células Tema 13 de Biología NS Diploma BI Curso 2013-2015 Diversidad del dominio Eubacteria Grupo muy amplio de bacterias que, debido a su gran variedad genética, participan
Métodos para estudiar las células
 Métodos para estudiar las células Sumario Historia de la Teoría Celular Estructura y función celular Transporte celular Métodos para estudiar las células El microscopio compuesto de luz El microscopio
Métodos para estudiar las células Sumario Historia de la Teoría Celular Estructura y función celular Transporte celular Métodos para estudiar las células El microscopio compuesto de luz El microscopio
Técnicas de Estudio de las células
 Técnicas de Estudio de las células Microscopia Preparaciones permanentes: Fijación Deshidratación Inclusión Corte Fijación: Acidos, solventes orgánicos como alcohol, aldehídos (Formaldehído, glutaraldehídos)
Técnicas de Estudio de las células Microscopia Preparaciones permanentes: Fijación Deshidratación Inclusión Corte Fijación: Acidos, solventes orgánicos como alcohol, aldehídos (Formaldehído, glutaraldehídos)
NORMAS DE UTILIZACION Y CONSERVACION DE LOS DESINFECTANTES.
 1 NORMAS DE UTILIZACION Y CONSERVACION DE LOS DESINFECTANTES. Desinfectante: sustancia química que destruye los microorganismos y que se aplica sobre material inerte sin alterarlo de forma sensible. Niveles
1 NORMAS DE UTILIZACION Y CONSERVACION DE LOS DESINFECTANTES. Desinfectante: sustancia química que destruye los microorganismos y que se aplica sobre material inerte sin alterarlo de forma sensible. Niveles
CURSO TEORICO-PRÁCTICO SOBRE MICROSCOPIA Y RECUENTO DE LEVADURAS PARA PRODUCTORES DE CERVEZA
 CURSO TEORICO-PRÁCTICO SOBRE MICROSCOPIA Y RECUENTO DE LEVADURAS PARA PRODUCTORES DE CERVEZA AUTORES: Diego Libkind Celia Tognetti Martin Moliné Laboratorio de Microbiologia Aplicada y Biotecnología Instituto
CURSO TEORICO-PRÁCTICO SOBRE MICROSCOPIA Y RECUENTO DE LEVADURAS PARA PRODUCTORES DE CERVEZA AUTORES: Diego Libkind Celia Tognetti Martin Moliné Laboratorio de Microbiologia Aplicada y Biotecnología Instituto
PRACTICA Núm. 15 AISLAMIENTO E IDENTIFICACION DE MOHOS DEL AIRE
 I. OBJETIVO PRACTICA Núm. 15 AISLAMIENTO E IDENTIFICACION DE MOHOS DEL AIRE Aislar mohos del aire y conocer sus características morfológicas y estructurales para lograr su identificación. II. INTRODUCCION
I. OBJETIVO PRACTICA Núm. 15 AISLAMIENTO E IDENTIFICACION DE MOHOS DEL AIRE Aislar mohos del aire y conocer sus características morfológicas y estructurales para lograr su identificación. II. INTRODUCCION
1. ESTUDIO DEL YOGUR.
 Un año más y continuando la línea investigadora que se lleva realizando entre los últimos años en La Anunciata Ikastetxea de Donostia nos hemos lanzado a la investigación. Durante el curso 2008-2009 el
Un año más y continuando la línea investigadora que se lleva realizando entre los últimos años en La Anunciata Ikastetxea de Donostia nos hemos lanzado a la investigación. Durante el curso 2008-2009 el
Esmalte Directo Sobre Hierro y Óxido Forja
 Esmalte Directo Sobre Hierro y Óxido Forja DEFINICIÓN PRODUCTO Óxido brinda una protección óptima de hasta 8 años a las barandillas y rejas de metal. Su fórmula especial actúa a la vez como fondo eficaz
Esmalte Directo Sobre Hierro y Óxido Forja DEFINICIÓN PRODUCTO Óxido brinda una protección óptima de hasta 8 años a las barandillas y rejas de metal. Su fórmula especial actúa a la vez como fondo eficaz
APÉNDICE G. Identificación bioquímica de enterobacterias por el sistema API 20E
 APÉNDICE G Identificación bioquímica de enterobacterias por el sistema API 20E OBJETIVO: - Establecer la metodología en la identificación de enterobacterias por medio de pruebas bioquímicas estandarizadas
APÉNDICE G Identificación bioquímica de enterobacterias por el sistema API 20E OBJETIVO: - Establecer la metodología en la identificación de enterobacterias por medio de pruebas bioquímicas estandarizadas
Células. 2ª Parte: Células procariotas. Tema 13 de Biología NS Diploma BI Curso
 Células 2ª Parte: Células procariotas Tema 13 de Biología NS Diploma BI Curso 2012-2014 Estructura de la célula procariota: Escherichia coli Las bacterias son las células procariotas típicas. Tienen pequeño
Células 2ª Parte: Células procariotas Tema 13 de Biología NS Diploma BI Curso 2012-2014 Estructura de la célula procariota: Escherichia coli Las bacterias son las células procariotas típicas. Tienen pequeño
Técnicas histológicas
 ATLAS de HISTOLOGÍA VEGETAL y ANIMAL Técnicas histológicas INCLUSIÓN Manuel Megías, Pilar Molist, Manuel A. Pombal Departamento de Biología Funcional y Ciencias de la Salud. Facultad de Biología. Universidad
ATLAS de HISTOLOGÍA VEGETAL y ANIMAL Técnicas histológicas INCLUSIÓN Manuel Megías, Pilar Molist, Manuel A. Pombal Departamento de Biología Funcional y Ciencias de la Salud. Facultad de Biología. Universidad
Ejercicio 3. La Célula (Capítulo 7) Preparado por: Prof. Ángel A. Ortiz-Vélez
 Universidad de Puerto Rico en Ponce: Departamento de Biología: BIOL 3013: 2004-2005 Ejercicio 3. La Célula (Capítulo 7) Preparado por: Prof. Ángel A. Ortiz-Vélez Introducción Células Procarioticas La célula
Universidad de Puerto Rico en Ponce: Departamento de Biología: BIOL 3013: 2004-2005 Ejercicio 3. La Célula (Capítulo 7) Preparado por: Prof. Ángel A. Ortiz-Vélez Introducción Células Procarioticas La célula
Práctica Nº 2 Pruebas para determinación del riesgo de caries dental
 Universidad de Los Andes Facultad de Odontología Microbiología Postgrado en Rehabilitación Bucal 2011 Práctica Nº 2 Pruebas para determinación del riesgo de caries dental Profesores: Lic. Leonidas E. Urdaneta
Universidad de Los Andes Facultad de Odontología Microbiología Postgrado en Rehabilitación Bucal 2011 Práctica Nº 2 Pruebas para determinación del riesgo de caries dental Profesores: Lic. Leonidas E. Urdaneta
EXTRACCIÓN DE ADN DE HONGOS FILAMENTOSOS
 EXTRACCIÓN DE ADN DE HONGOS FILAMENTOSOS Los hongos poseen un genoma complejo consistente en: ADN nuclear (n ADN) ADN mitocondrial (mt ADN) en algunos casos ADN plasmídico EXTRACCIÓN DE ADN DE HONGOS FILAMENTOSOS
EXTRACCIÓN DE ADN DE HONGOS FILAMENTOSOS Los hongos poseen un genoma complejo consistente en: ADN nuclear (n ADN) ADN mitocondrial (mt ADN) en algunos casos ADN plasmídico EXTRACCIÓN DE ADN DE HONGOS FILAMENTOSOS
PROCEDIMIENTO RECUENTO DE COLIFORMES EN MEDIO SÓLIDO
 PRT-712.03-008 Página 1 de 6 1. OBJETIVO Este método es utilizado para realizar recuento de bacterias del grupo coliformes, como indicador sanitario. 2. CAMPO DE APLICACIÓN Y ALCANCE Aplicar este procedimiento
PRT-712.03-008 Página 1 de 6 1. OBJETIVO Este método es utilizado para realizar recuento de bacterias del grupo coliformes, como indicador sanitario. 2. CAMPO DE APLICACIÓN Y ALCANCE Aplicar este procedimiento
Práctica 4 :Diversidad celular
 Práctica 4 :Diversidad celular I. OBJETIVOS Al final del laboratorio el estudiante debe ser capaz de: * Aplicar los procedimientos para preparar materiales y observarlos en el microscopio. * Identificar
Práctica 4 :Diversidad celular I. OBJETIVOS Al final del laboratorio el estudiante debe ser capaz de: * Aplicar los procedimientos para preparar materiales y observarlos en el microscopio. * Identificar
1. Explica la diferencia entre el tejido epitelial de revestimiento y el glandular. Indica algún ejemplo de cada uno de ellos.
 ACTIVIDADES DE ENSEÑANZA-APRENDIZAJE HISTOLOGÍA De refuerzo 1. Explica la diferencia entre el tejido epitelial de revestimiento y el glandular. Indica algún ejemplo de cada uno de ellos. Aunque existen
ACTIVIDADES DE ENSEÑANZA-APRENDIZAJE HISTOLOGÍA De refuerzo 1. Explica la diferencia entre el tejido epitelial de revestimiento y el glandular. Indica algún ejemplo de cada uno de ellos. Aunque existen
Enfocados en las células
 00 100 0-100 -00 with chemoattractant -100-0 0 0 100 00 100 0-100 -00 x displacement [µm] without chemoattractant -100-0 0 0 100 Enfocados en las células Microscopía celular perfecto crecimiento celular
00 100 0-100 -00 with chemoattractant -100-0 0 0 100 00 100 0-100 -00 x displacement [µm] without chemoattractant -100-0 0 0 100 Enfocados en las células Microscopía celular perfecto crecimiento celular
SEPARACIÓN DE ASPIRINA, ACETOFENITIDINA Y CAFEÍNA POR CROMATOGRAFÍA DE CAPA FINA
 Facultad de Farmacia Departamento de Química Física Universidad de Granada PRÁCTICA 3 SEPARACIÓN DE ASPIRINA, ACETOFENITIDINA Y CAFEÍNA POR CROMATOGRAFÍA DE CAPA FINA Introducción A menudo, la aspirina,
Facultad de Farmacia Departamento de Química Física Universidad de Granada PRÁCTICA 3 SEPARACIÓN DE ASPIRINA, ACETOFENITIDINA Y CAFEÍNA POR CROMATOGRAFÍA DE CAPA FINA Introducción A menudo, la aspirina,
TÉCNICOS DE ANATOMÍA PATOLÓGICA DEL SERVICIO CANARIO DE SALUD TEST APÉNDICE
 TÉCNICOS DE ANATOMÍA PATOLÓGICA DEL SERVICIO CANARIO DE SALUD TEST APÉNDICE Edición marzo 2010 Apéndice del libro de test TEST N.º 1. Epidemiología y método epidemiológico. Epidemiología de las enfermedades
TÉCNICOS DE ANATOMÍA PATOLÓGICA DEL SERVICIO CANARIO DE SALUD TEST APÉNDICE Edición marzo 2010 Apéndice del libro de test TEST N.º 1. Epidemiología y método epidemiológico. Epidemiología de las enfermedades
PRÁCTICA PARA EL ESTUDIO DE CULTIVOS BACTERIANOS PUROS (Siembra)
 PRÁCTICA PARA EL ESTUDIO DE CULTIVOS BACTERIANOS PUROS (Siembra) OBJETIVOS GENERALES. Al finalizar este ejercicio el alumno será capaz de: Aplicar las diferentes técnicas de siembra que se emplean para
PRÁCTICA PARA EL ESTUDIO DE CULTIVOS BACTERIANOS PUROS (Siembra) OBJETIVOS GENERALES. Al finalizar este ejercicio el alumno será capaz de: Aplicar las diferentes técnicas de siembra que se emplean para
PROLOGO NOMBRE DEL ALUMNO: PROFESOR DE TEORÍA: PROFESORES DE LABORATORIO: GRUPO: PERIODO LECTIVO: CARRERA: ESCUELA:
 PROLOGO El presente libro tiene la finalidad de dar apoyo a las asignaturas relacionadas con el cultivo, manejo, aislamiento, conservación e identificación de microorganismos para los estudiantes de educación
PROLOGO El presente libro tiene la finalidad de dar apoyo a las asignaturas relacionadas con el cultivo, manejo, aislamiento, conservación e identificación de microorganismos para los estudiantes de educación
MANUAL DE LABORATORIO DE TÉCNICAS MICROBIOLÓGICAS
 INSTITUTO POLITÉCNICO NACIONAL UNIDAD PROFESIONAL INTERDISCIPLINARIA DE BIOTECNOLOGÍA DEPARTAMENTO DE CIENCIAS BÁSICAS ACADEMIA DE MICROBIOLOGÍA MANUAL DE LABORATORIO DE TÉCNICAS MICROBIOLÓGICAS PRIMERA
INSTITUTO POLITÉCNICO NACIONAL UNIDAD PROFESIONAL INTERDISCIPLINARIA DE BIOTECNOLOGÍA DEPARTAMENTO DE CIENCIAS BÁSICAS ACADEMIA DE MICROBIOLOGÍA MANUAL DE LABORATORIO DE TÉCNICAS MICROBIOLÓGICAS PRIMERA
